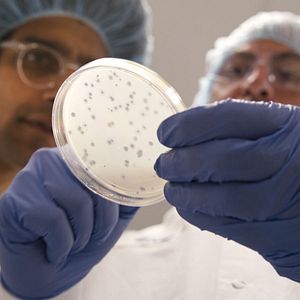
Bilder Vernetzt - Wissenschaft ist überall

6 Episoden
zuerst ausgestrahlt auf: Netflix
Starttermin: 2. August 2020
5 Bilder
Alle Bilder zur Staffel 1